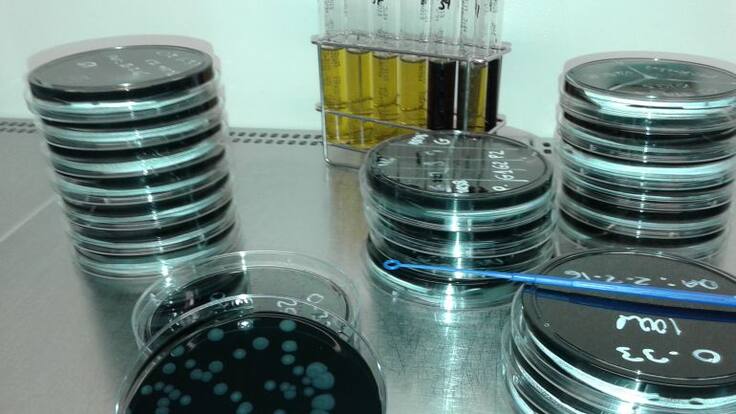

Mesa de España del 12 de abril de 2016
Ya llegan al centenar las denuncias que se van a presentar en los juzgados por el brote de legionela de Manzanares, en Ciudad Real, que afectó a más de 200 personas y que provocó la muerte de cuatro. Esta es una de las historias de la Mesa de España:
- Esta noche han sido trasladados al puerto de Motril, en Granada, los 26 inmigrantes de una patera rescatada por Salvamento Marítimo en el mar de Alborán.
- La alcaldesa de Madrid, Manuela Carmena, le ha enviado una carta al presidente, Mariano Rajoy, para pedirle que desbloquee la llegada de refugiados a España.
- Arcelor ha apagado el horno de Zumarraga, en Gipuzkoa, e inicia de esta forma el cierre de la fábrica. La multinacional negocia ahora la recolocación de sus más de 300 trabajadores.
- Una veintena de extranjeros, la mayoría búlgaros, están siendo investigados por darse de alta como falsos autónomos para entrar en la lista de espera de trasplantes.
- Ha comenzado el juicio contra los mossos acusados de reventarle un ojo a una mujer con una pelota de goma durante la segunda huelga general de 2012. Hoy escucharemos el testimonio de la víctima.
- La policía nacional ha cerrado una web de descargas piratas que ofrecía miles de películas y series en español. El administrador de la página ha sido detenido en Valladolid.
- En otra operación contra el narcotráfico, la policía ha detenido a cinco personas en Madrid y Toledo tras desmantelar un laboratorio de cocaína.
- La Audiencia de Bizkaia ha suspendido una pena de cuatro años de cárcel a un traficante drogadicto con la condición de que siga un tratamiento para desintoxicarse.
- Con la música a otra parte. El Ayuntamiento de Torrelavega, en Cantabria, va a instalar contenedores de transporte marítimo junto a la Universidad para que los jóvenes músicos puedan ensayar.




